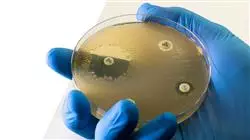
##IMAGE##

Universitäre Qualifikation
Die größte Fakultät für Krankenpflege der Welt"
Präsentation
Dank dieses Universitätskurses, der auf Relearning basiert, werden Sie bakterielle Infektionen mit Hilfe der neuen antimikrobiellen Moleküle wirksam diagnostizieren können“

Die Weltgesundheitsorganisation sieht in der antimikrobiellen Resistenz eine der größten Herausforderungen für die globale öffentliche Gesundheit. Demnach könnten Infektionen, die durch Antibiotikaresistenzen verursacht werden, in den kommenden Jahren jährlich bis zu 10 Millionen Todesfälle verursachen. Als Reaktion auf diese Krise hat die Wissenschaft Neue Antimikrobielle Moleküle für die Krankenpflege entwickelt, die Hoffnung im Kampf gegen resistente Krankheitserreger geben. Der Erfolg hängt jedoch weitgehend von einer ordnungsgemäßen Verwaltung und Überwachung ab. Daher ist es für Pflegekräfte unerlässlich, über diese Entwicklungen informiert zu sein, um die Qualität der Pflege für ihre Patienten zu verbessern.
In diesem Zusammenhang präsentiert TECH einen revolutionären Universitätskurs in Neue Antimikrobielle Moleküle für die Krankenpflege für die Krankenpflege. Der Studiengang wird sich mit den Methoden zur Entdeckung dieser Elemente befassen und sich dabei auf Aspekte wie die Fortschritte in der Screening-Technologie, das Design von Medikamenten und die funktionelle Genomik konzentrieren. In diesem Zusammenhang wird eine breite Palette neuer Arzneimittel (u. a. Penicilline, zyklische Lipopeptide und Monobactame) mit einer eingehenden Analyse ihrer Wirkungsmechanismen, therapeutischen Anwendungen und unerwünschten Wirkungen erörtert.
Während des Programms erwerben die Studenten die Kompetenz, Protokolle zur Infektionsprävention und -kontrolle anzuwenden.
Außerdem wird das Universitätsprogramm zu 100% online unterrichtet. Dies ermöglicht es den Pflegekräften, ihr Studium mit ihren sonstigen regulären Aufgaben zu vereinbaren, da die Prüfungszeitpläne und Stundenpläne individuell geplant werden können. Gleichzeitig benötigen sie nur ein Gerät mit Internetzugang, um auf den virtuellen Campus zuzugreifen und qualitativ hochwertige Inhalte abzurufen. In dieser digitalen Umgebung finden sie auch eine Bibliothek voller multimedialer Ressourcen, wie Infografiken oder interaktive Zusammenfassungen, die ihre Kompetenzen auf dynamische Weise stärken werden.
Sie werden die besten Multimedia-Ressourcen zur Verfügung haben, um Ihr Lernen zu bereichern und das Gelernte viel einfacher in die Praxis umzusetzen“
Dieser Universitätskurs in Neue Antimikrobielle Moleküle für die Krankenpflege enthält das vollständigste und aktuellste wissenschaftliche Programm auf dem Markt. Die wichtigsten Merkmale sind:
- Entwicklung von Fallstudien, die von Experten für Mikrobiologie, Medizin und Parasitologie vorgestellt werden
- Der anschauliche, schematische und äußerst praxisnahe Inhalt vermittelt alle für die berufliche Praxis unverzichtbaren wissenschaftlichen und praktischen Informationen
- Die praktischen Übungen, bei denen der Selbstbewertungsprozess zur Verbesserung des Lernens durchgeführt werden kann
- Sein besonderer Schwerpunkt liegt auf innovativen Methoden
- Theoretische Lektionen, Fragen an den Experten, Diskussionsforen zu kontroversen Themen und individuelle Reflexionsarbeit
- Die Verfügbarkeit des Zugriffs auf die Inhalte von jedem festen oder tragbaren Gerät mit Internetanschluss
Sie erhalten einen Einblick in die innovativsten Strategien für rationales Design von Medikamenten“
Das Dozententeam des Programms besteht aus Experten des Sektors, die ihre Berufserfahrung in diese Fortbildung einbringen, sowie aus renommierten Fachkräften von führenden Gesellschaften und angesehenen Universitäten.
Die multimedialen Inhalte, die mit der neuesten Bildungstechnologie entwickelt wurden, werden der Fachkraft ein situiertes und kontextbezogenes Lernen ermöglichen, d. h. eine simulierte Umgebung, die eine immersive Fortbildung bietet, die auf die Ausführung von realen Situationen ausgerichtet ist.
Das Konzept dieses Programms konzentriert sich auf problemorientiertes Lernen, bei dem die Fachkraft versuchen muss, die verschiedenen Situationen aus der beruflichen Praxis zu lösen, die während des gesamten Studiengangs gestellt werden. Zu diesem Zweck wird sie von einem innovativen interaktiven Videosystem unterstützt, das von renommierten Experten entwickelt wurde.
Möchten Sie Fähigkeiten entwickeln, um die wissenschaftlichen Erkenntnisse im Zusammenhang mit neuen antimikrobiellen Molekülen zu interpretieren? Erreichen Sie es mit diesem Programm in nur 180 Stunden"

Die 100%ige Methodik dieses Studiengangs ermöglicht es Ihnen, hervorragend zu lernen, ohne sich an genaue, vorher festgelegte Zeitpläne zu halten"
Lehrplan
Mit diesem Hochschulabschluss verfügen die Pflegekräfte über ein solides Verständnis der Wirkungsmechanismen neuer antimikrobieller Moleküle. Der Lehrplan sieht eine umfassende Analyse neuer Medikamente wie Penicilline, Cephalosporine oder Carbapenemika im Hinblick auf ihr antimikrobielles Spektrum und ihren therapeutischen Einsatz vor. Während des Programms werden die Studenten fortgeschrittene Kompetenzen entwickeln, um antimikrobielle Behandlungen auf der Grundlage des klinischen Profils der Patienten und der Ergebnisse von Empfindlichkeitstests auf Bakterien zu individualisieren. Darüber hinaus werden die Herausforderungen und Möglichkeiten bei der Entwicklung neuer antimikrobieller Moleküle erörtert.

Sie können Protokolle zur Infektionsprävention, die den Einsatz neuer antimikrobieller Moleküle vorsehen, umsetzen und überwachen“
Modul 1. Neue antimikrobielle Moleküle
1.1. Neue antimikrobielle Moleküle
1.1.1. Der Bedarf an neuen antimikrobiellen Molekülen
1.1.2. Auswirkungen neuer Moleküle auf die antimikrobielle Resistenz
1.1.3. Herausforderungen und Chancen bei der Entwicklung neuer antimikrobieller Moleküle
1.2. Methoden für die Entdeckung neuer antimikrobieller Moleküle
1.2.1. Traditionelle Ansätze zur Entdeckung
1.2.2. Fortschritte in der Screening-Technologie
1.2.3. Rationale Strategien zur Entwicklung von Arzneimitteln
1.2.4. Biotechnologie und funktionelle Genomik
1.2.5. Andere innovative Ansätze
1.3. Neue Penicilline: Neue Medikamente und ihre künftige Rolle in der Antiinfektivatherapie
1.3.1. Klassifizierung
1.3.2. Wirkungsmechanismus
1.3.3. Antimikrobielles Spektrum
1.3.4. Therapeutische Anwendungen
1.3.5. Nebenwirkungen
1.3.6. Präsentation und Dosierung
1.4. Cephalosporine
1.4.1. Klassifizierung
1.4.2. Wirkungsmechanismus
1.4.3. Antimikrobielles Spektrum
1.4.4. Therapeutische Anwendungen
1.4.5. Nebenwirkungen
1.4.6. Präsentation und Dosierung
1.5. Carbapenemika und Monobactame
1.5.1. Klassifizierung
1.5.2. Wirkungsmechanismus
1.5.3. Antimikrobielles Spektrum
1.5.4. Therapeutische Anwendungen
1.5.5. Nebenwirkungen
1.5.6. Präsentation und Dosierung
1.6. Zyklische Glykopeptide und Lipopeptide
1.6.1. Klassifizierung
1.6.2. Wirkungsmechanismus
1.6.3. Antimikrobielles Spektrum
1.6.4. Therapeutische Anwendungen
1.6.5. Nebenwirkungen
1.6.6. Präsentation und Dosierung
1.7. Makrolide, Ketolide und Tetrazykline
1.7.1. Klassifizierung
1.7.2. Wirkungsmechanismus
1.7.3. Antimikrobielles Spektrum
1.7.4. Therapeutische Anwendungen
1.7.5. Nebenwirkungen
1.7.6. Präsentation und Dosierung
1.8. Aminoglykoside und Quinolone
1.8.1. Klassifizierung
1.8.2. Wirkungsmechanismus
1.8.3. Antimikrobielles Spektrum
1.8.4. Therapeutische Anwendungen
1.8.5. Nebenwirkungen
1.8.6. Präsentation und Dosierung
1.9. Lincosamide, Streptogramine und Oxazolidinone
1.9.1. Klassifizierung
1.9.2. Wirkungsmechanismus
1.9.3. Antimikrobielles Spektrum
1.9.4. Therapeutische Anwendungen
1.9.5. Nebenwirkungen
1.9.6. Präsentation und Dosierung
1.10. Rifamycine und andere neue antimikrobielle Moleküle
1.10.1. Rifamycine: Klassifizierung
1.10.1.2. Wirkungsmechanismus
1.10.1.3. Antimikrobielles Spektrum
1.10.1.4. Therapeutische Anwendungen
1.10.1.5. Nebenwirkungen
1.10.1.6. Präsentation und Dosierung
1.10.2. Antibiotika natürlichen Ursprungs
1.10.3. Synthetische antimikrobielle Mittel
1.10.4. Antimikrobielle Peptide
1.10.5. Antimikrobielle Nanopartikel
Dieser Studiengang bereitet Sie darauf vor, die Herausforderungen im Bereich der neuen antimikrobiellen Moleküle zu meistern. Schreiben Sie sich jetzt ein und erleben Sie sofortige Fortschritte in Ihrer Karriere als Pflegekraft!“
Universitätskurs in Neue Antimikrobielle Moleküle für die Krankenpflege
Entdecken Sie den innovativen Universitätskurs in Neue Antimikrobielle Moleküle für die Krankenpflege der TECH Technologischen Universität. Dieses Programm richtet sich an Pflegefachkräfte, die ihre Kenntnisse und die Anwendung der neuesten Forschungsergebnisse auf dem Gebiet der klinischen Mikrobiologie und der antimikrobiellen Therapien vertiefen möchten. Der Online-Unterricht, den unsere Hochschule anbietet, gibt Ihnen die Flexibilität, von überall aus zu studieren und sich an Ihren Zeitplan und Ihre beruflichen Verpflichtungen anzupassen. Durch eine fortschrittliche virtuelle Lernumgebung haben Sie Zugang zu hochwertigen Lehrinhalten, die von Experten auf dem Gebiet vermittelt werden. Der Kurs behandelt wichtige Themen wie die Entwicklung neuer antimikrobieller Moleküle, ihre Wirkmechanismen, klinische Anwendungen und die Bedeutung eines verantwortungsvollen Umgangs mit diesen Wirkstoffen in der Pflegepraxis. Sie lernen, wie Sie die Wirksamkeit und Sicherheit dieser Behandlungen kritisch bewerten und wie Sie die besten Praktiken in die Pflege von Patienten mit resistenten Infektionen integrieren können.
Erweitern Sie Ihr Wissen über antimikrobielle Moleküle
Wissen Sie, warum TECH als eine der besten Universitäten der Welt gilt? Weil wir über einen Katalog von mehr als zehntausend akademischen Programmen, eine Präsenz in mehreren Ländern, innovative Methoden, eine einzigartige akademische Technologie und ein hochqualifiziertes Dozententeam verfügen; deshalb dürfen Sie sich die Gelegenheit, bei uns zu studieren, nicht entgehen lassen. Dieser Studiengang zeichnet sich durch seinen praktischen und evidenzbasierten Ansatz aus, der Sie auf die aktuellen und zukünftigen Herausforderungen im Bereich der Krankenpflege vorbereitet. Sie werden auch die Möglichkeit haben, mit Fachleuten aus der ganzen Welt zusammenzuarbeiten, was Ihre Bildungserfahrung bereichert und Ihr Netzwerk erweitert. Nach Abschluss des Kurses werden Sie in der Lage sein, Ihr Wissen über effektiven Umgang mit antimikrobiellen Mitteln anzuwenden und zur Weiterentwicklung der Pflegepraxis im Bereich der antimikrobiellen Infektionen beizutragen. Mit dem Universitätskurs in Neue Antimikrobielle Moleküle für die Krankenpflege können Sie Ihre Karriere ankurbeln und etwas im Gesundheitswesen bewegen.







